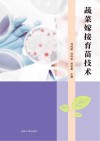
蔬菜嫁接育苗技术 封面

蔬菜嫁接育苗技术
作者: 马纯明,付伟宗,郑秋香主编
ISBN:978-7-206-18783-4
关键词: 蔬菜-嫁接;蔬菜-育苗
页数:161
出版社: 长春:吉林人民出版社
出版日期:
发现《蔬菜嫁接育苗技术》在 2025-10-28 可全文阅读或下载。
图书简介
蔬菜嫁接育苗技术
用户须知
出版社通过教客网下载电子书并起诉站长多次,本站随时可能倒闭。
诉讼案号:(2022)川01民初4401,(2022)川01民初4403,(2022)川01民初4403,(2022)川0191民初19351号, (2022)川0191民初19594号,(2022)川0191民初20457号,(2022)川0191民初20459号, (2023)川知民终373号,(2023)川知民终374号,(2023)川知民终375号, (2024)川0191民初15977号,(2024)川0191民初15979号,(2024)川0191民初15980号, (2024)川0191民初15981号,(2024)川0191民初15982号
- 如果要找《蔬菜嫁接育苗技术》,可以尝试去图书馆。
- 本页面文字内容和图片来自 m.5read.com。
- 封皮图片引用地址:https://cover.duxiu.com/coverNew/CoverNew.dll?iid=6a676064666560636167579fa090a892a596a39e92a39c3236323234313631
